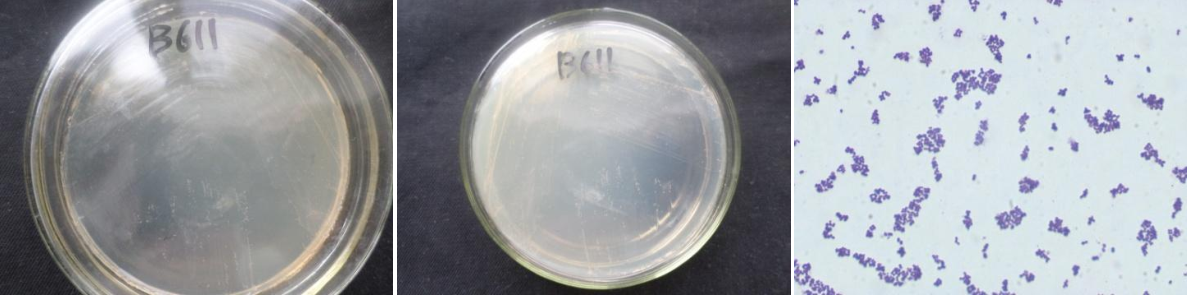

Loading...
| StrainNO | B611 |
| Classification | Salinicoccus |
| 16s rDNA sequence | CCCGTAGGCTCCTTGTTCGACTTCACCCCAATCATCGGTCCCACCTTCGACGGCTGCCTCCAAGAGGTTGGCCCACCGGCTTCAG GTGTTACCGACTTTCGTGGGGTGACGGGCGGTGTGTACAAGACCCGGGAACGTATTCACCGTGGCATTCTGATCCACGATTACTA GCGATTCCAGCTTCATGGAGTCGAGTTGCAGACTCCAATCCGAACTGAGAACAGTTTTATGGGATTCGCTTGGCCTCGCGGCGTA GCTGCCCTTTGTCACCTGTCCATTGTAGCACGTGTGTAGCCCAAATCATAAGGGGCATGATGATTTGACGTCATCCCCACCTTCC TCCGGTTTGTCACCGGCAGTCTCACTAGAGTGCCCAACTGAATGCTGGCAACTAGTGATAAGGGTTGCGCTCGTTGCGGGACTTA ACCCAACATCTCACGACACGAGCTGACGACAACCATGCACCACCTGTCACTCTGCCCCGAAGGGAAACCCTGTCTCCAGGGTGGT CAGAGGATGTCAAGATTTGGTAAGGTTCTTCGCGTTGCTTCGAATTAAACCACATGCTCCACCGCTTGTGCGGGTCCCCGTCAAT TCCTTTGAGTTTCAACCTTGCGGCCGTACTCCCCAGGCGGAGTGCTTAATGCGTTATCTGCAGCACTAAGGGGCGGAAACCCCCT AACACTTAGCACTCATCGTTTACGGCGTGTACTACCACGGTATCTAATCCTGTTTGATCCCCACGCTTTCGCACCTCAGCGTCAG TTGCAGACCAGAGAGCCGCCTTCGCCACTGGTGTTCCTCCATATCTCTGCGCATTTCACCCGCTACACATGGAATTCCACTCTCC TCTTCTGCACTCAAGTCCGCCAGTTTCCAATGACCCTCCCCGGTGGAGCCGGGCTTTCACATCAGACTTAACGAACCGCCTACGC GCGCTTTACGCCCAATAATTCCGATACGCTTGCCCCCTACGTATACCGCGCTGCTGGCACGTAGTAGCCGTGCTTTCTTGTCAGG TACCGTCACCCGACGGCAGTTACTCCCGTCCGGGTTTTTCCTGAACAGAAGTTACAAGCGAACTCTTTATTAGCGGGTTTCCGCT GACTTTTCCATTGGAAATTCCTAATGGTGTCTCCTAGGACTGGGCGGTCCTATCCGAGTGGCAACCCTCTAAGTGTACACATTGC CTGTGGGCTTCCCCCA |
| Strain Morphology Photos | |
| Morphological Description | Colony round;Pink White;edge neatly;steamed bun shaped;slippy;sticky;Waxed:Ball-shaped;no spore |